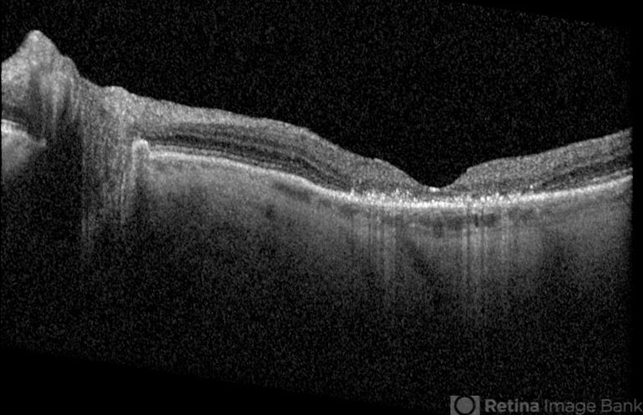

-
 By Marina Gilca, MD
By Marina Gilca, MD
Retina Consultants LTD
Co-author(s): Max Johnson, MD; Retina Consultants, Fargo, ND - Uploaded on Dec 5, 2017.
- Last modified by Marina Gilca, MD on Apr 25, 2018.
- Rating
- Appears in
- Susac Syndrome
- Condition/keywords
- plaquenil toxicity
- Photographer
- Retina Consultants LTD
- Imaging device
- Optical coherence tomography system
- Description
- Plaquenil toxicity

Initializing download.
Initializing download.

